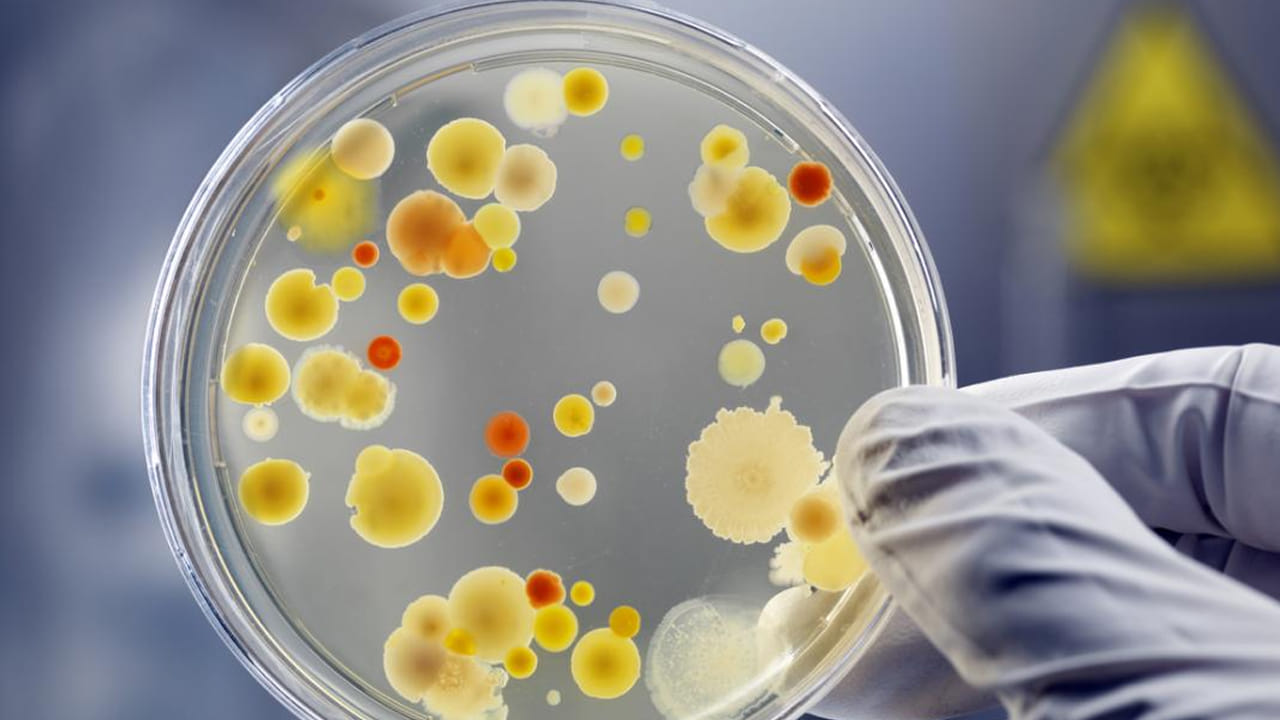
ఇదిలా తాజాగా వెలువడిన సర్వే వివరాల ప్రకారం ఒక్క యాపిల్ లో కోట్ల బ్యాక్టీరియా ఉంటుందని చెబుతున్నారు నిపుణులు. మరి ఈ బ్యాక్టీరియా మనకు మంచి చేస్తుందా, చెడును కలుగజేస్తుందా అన్నది అందరికీ ఆసక్తిని కలిగించే విషయం.

ఆపిల్ పండులో కోట్ల సంఖ్యలో బ్యాక్టీరియా.. తింటే ఏమవుతుందో తెలుసా..
ఆపిల్ పండు తెలియని వారు ఉండరు. ఎర్రగా నిగనిగలాడుతూ అందరినీ ఆకర్షిస్తుంది ఆపిల్. ఇది ఆరోగ్యం కాపాడటంలో కూడా అనేక రకాలుగా ఉపయోగపడుతుందని చెబుతారు వైద్యనిపుణులు. ఇందులోని యాంటీఆక్సిడెంట్స్ శరీరంలో పేరుకున్న కొవ్వును కరిగించడంలో దోహదపడుతుంది. ప్రతి రోజూ ఒక గుడ్డు లాగా రోజుకో ఆపిల్ తింటే సంపూర్ణ ఆరోగ్యం పక్కా అంటూ ఉంటారు డాక్టర్లు.

1 / 5

2 / 5
3 / 5

4 / 5

5 / 5
Follow Us
